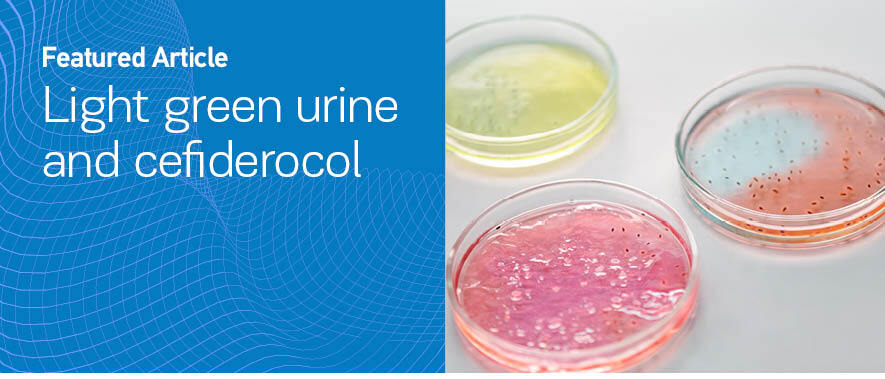

INTRODUCTION
Cefiderocol is a novel antimicrobial used for difficult-to-treat infections (DTR) caused by extremely drug-resistant gram-negative bacteria. It is a novel siderophore cephalosporin which has shown in vitro activity against strains that are carbapenemase producers, including those that produce metallo-β-lactamases such as imipenemase, New Delhi metallo-β-lactamase (NDM), and Verona integron-encoded metallo-β-lactamase1. In Greece, epidemiology of gram-negative bacteria is characterized by multi and pan resistant strains and cefiderocol may be needed for treating such infections. Although cefiderocol has been recently introduced to the therapeutic armamentarium, some cases presenting several urine discoloration have been described in literature. Some of them have been associated with blood transfusions, gastrointestinal bleeding or ferric gluconate administration, some others not. The urine color in all these cases was either dark brown or black or dark red. We herein describe the first case of light green discoloration associated with cefiderocol administration.
CASE PRESENTATION
A 72-year-old female was brought to the Emergency department because of progressive shortness of breath, orthopnea, cough with purulent sputum, weakness, and vaginal bleeding. Her past medical history included atrial fibrillation, diabetes mellitus, hypothyroidism, and recurrent vaginal bleeding. Due to severe untreated depression, the patient had neglected all her medical problems. Soon after her arrival in the emergency department she was intubated because of hypercapnia, hypoxemia, low Glasgow coma scale (CGS 3/15) and severe hemodynamic instability. A PCR test performed for COVID-19 turned positive. The chest C/T revealed the presence of pneumonia in lingula with bilateral pleural effusion, ground glass opacities localized to the right lung, and peripherally scattered infiltrates. She was then admitted to the Intensive Care Unit and treated accordingly.
Due to difficulty in weaning from mechanical ventilation, her ICU stay was prolonged, and she was submitted to a tracheostomy. Her hospitalization was complicated by several episodes of ventilator-associated pneumonia and bloodstream infections caused by DTR (difficult to treat) bacteria. On the 50th day of her hospitalization, blood cultures were obtained because the patient presented a high body temperature. The blood cultures revealed the presence of an extremely drug resistant Klebsiella pneumonia isolate. The isolate was only susceptible to cefiderocol and amikacin and a treatment including those two antimicrobials was started. The cefiderocol dose was 2 g t.i.d. On the 12th day of treatment, a light green urine discoloration was noticed (Figure 1). The patient had a urinary catheter in place and urinalysis demonstrated a pH 5, while the rest of the findings included 5/hpf red blood cells and 1/hpf white blood cells, trace blood, no bilirubin, and no bacteria. Further investigation showed normal bilirubin and normal creatinine levels, so we suspected a side effect of a drug. Since the patient was not receiving propofol, a drug usual in ICU patients, a side effect of cefiderocol was suspected. The next day of treatment the urine color turned into a darker green discoloration (Figure 2). The day after, the treatment was completed and soon after that, the urine color turned yellow again.
DISCUSSION
A variety of medical conditions and medication may cause green urine discoloration. Urine tract infections caused by Pseudomonas aeruginosa and ingestion of artificial food dyes in high concentrations are some examples. Examples of medications include substances containing phenols such as methylene blue (a dye used during imaging procedures) promethazine, cimetidine and propofol2. Other non-phenolic medications which can cause green urine, include metoclopramide and amitriptyline. Finally, the presence of biliverdin, a product of bilirubin, that has a green hue is a possible consequence of presence of high bilirubin levels and may give the urine a green color.
In our case, the patient was not receiving any of these drugs while laboratory evaluation excluded any alternative cause. Thus, we suspected a rare side effect of cefiderocol, a novel antibiotic given to our patient. Her urine color turned back to yellow 72 hours after discontinuation of cefiderocol, further supporting our clinical assumption.
Cefiderocol is a siderophore cephalosporin with a novel mechanism for transport across the outer membrane that can overcome resistance mechanisms of carbapenem-resistant gram-negative bacteria, including efflux pump up-regulation and porin channel mutations. Siderophores are natural iron-chelating molecules that are released by bacteria to facilitate the transport of iron into the cell. Cefiderocol functions as a siderophore by binding to extracellular free ferric iron1,3.
Even though cefiderocol is excreted mainly by urine as an unchanged drug, urine discoloration in usual doses is rare in humans. Chromaturia has been described in dose toxicity studies conducted in animals (European Medicines Agency. Assessment report: Fetroja (https://www.ema.europa.eu/en/documents/assessment-report/fetcroja-epar-public-assessment-report_en.pdf), published 27 February 2020). Only a few cases have been described in humans. Lewis and Arnouk4 first described dark red urine in a patient treated with cefiderocol and ferric gluconate. The discoloration appeared after the first dose of ferric gluconate and urine returned to normal after completion of therapy4. A year later, Shapiro et al.5 presented their case series of 3 children who developed red wine urine syndrome during co-administration of cefiderocol and blood transfusion. Lupia et al.6 observed dark brown chromaturia in a patient receiving cefiderocol, a few hours after an event of gastrointestinal bleeding due to gastric ulcer. All these incidents seem to be related to cefiderocol’s mechanism of action. Ginaldi and De Martinis7, in a recent case report, found black urine in a patient treated with cefiderocol after a massive gastric bleeding treated with pantoprazole, suggesting that alkalinization due to proton pump inhibitors and the reabsorption of hemic iron induce the renal clearance of cefiderocol-ferric ion complexes. Lescroart et al.8 also described black urine in association with 500 mg ferric carboxymaltose IV given for post-operative iron deficiency anemia. Other investigators described urine discoloration (dark brown or purplish) simply as a drug side effect9,10.
To our knowledge this is the first case of green urine described after the use of cefiderocol. Since cefiderocol use is inevitably going to rise during the years to come because of resistance phenomenon in bacteria, physicians should be aware of this drug adverse effect and avoid needless investigations.
CONCLUSION
Drug induced urine discoloration is a rare, yet benign and self-limited adverse effect of cefiderocol. Sometimes it is related to conditions increasing serum iron concentration, such as upper gastrointestinal hemorrhage or blood transfusions, sometimes no other situation is apparently related. Physician awareness is important, to avoid unnecessary testing.